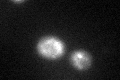
YLL015W

View description
ABC type transmembrane transporter of MRP/CFTR family, found in vacuolar membrane, involved in the transport of unconjugated bilirubin and in heavy metal detoxification via glutathione conjugates, along with Ycf1p
Localization:
Intensity:
Fold change:
Significance:
-
C’ GFP library in SD

vacuole membrane23.51 -
N' NOP1pr-GFP in SD

ER,punctate23.8861 -
N' TEF2pr-mCherry in SD

below threshold11.9224 -
N' NATIVEpr-GFP in SD

below threshold18.8267 -
N' TEF2pr-VC and Cyto-VN in SD

below threshold23.737 -
C’ GFP library in SD+DTT
vacuole membrane26.091.1No -
C’ GFP library in SD+H2O2

vacuole membrane27.331.16No -
C’ GFP library in Starvation Media

vacuole membrane27.481.16No -
C’ GFP library on the background of Pup2-DaMP

vacuole membrane -
C’ GFP library on the background of CCT mutant

vacuole membrane18.85450.801783No
